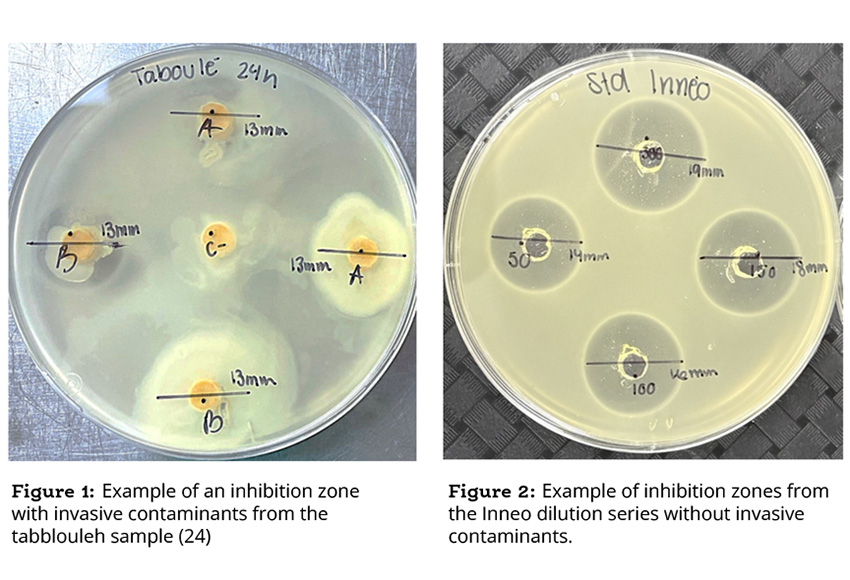

Abstract
This study evaluated whether Inneo maintains its antimicrobial activity when incorporated into a variety of ready-to-eat deli salads within the customer’s portfolio. Compatibility was assessed using a soft agar assay, which determines whether Inneo continues to inhibit Listeria monocytogenes after being mixed with different food matrices. Products included complete salads, dressings, dips, and acidified ingredients such as lemon juice and citric acid. Across all samples, Inneo consistently produced inhibition zones equivalent to the 50 ppm control, demonstrating that none of the matrices reduced its activity. No sensory or formulation changes were detected, confirming that Inneo can be incorporated into these products without affecting quality while still providing reliable antimicrobial protection.
Understanding compatibility testing
A compatibility test is a qualitative method used to confirm that an antimicrobial ingredient remains active when introduced into real food products. Food matrices can vary widely in composition, and components such as fats, proteins, acids, or spices can sometimes interfere with an antimicrobial’s ability to function. The soft agar method used in this study does not measure log reductions. Instead, it answers a more fundamental question: does Inneo still work as intended once mixed into this specific recipe? If the antimicrobial remains active, it will create a clear inhibition zone on the agar surface, visible as a circular area where Listeria monocytogenes cannot grow.
Methods
Several products from the customer’s range were evaluated, including mixed salads, spinach dip, quinoa and beet salad, tabbouleh, lemon juice, and citric acid solution. Each product was prepared with and without Inneo and stored for three hours and twenty-four hours at refrigerated temperatures. Before testing, samples were diluted to a final concentration of 50 ppm and deposited onto soft agar plates inoculated with Listeria monocytogenes J1-108. After incubation, inhibition diameters were measured to determine whether the antimicrobial remained active in each matrix.
Results
Table 1: Inhibition diameter against Listeria monocytogenes

*Presence of invasive contaminants that can interfere with results
Results
The results were consistent across all products. Inneo maintained its activity in every matrix, producing inhibition zones that matched the 50 ppm control both at three hours and twenty-four hours. Salads, dressings, and dips all demonstrated clear inhibitory effects once mixed with Inneo, and there was no evidence that any formulation interfered with antimicrobial performance. Lemon juice and citric acid both displayed some natural inhibitory activity, as expected. However, when Inneo was added, the inhibition zones increased noticeably, indicating that the antimicrobial remained fully active and in some cases showed a synergistic effect. A few salad samples contained background microbial contaminants, likely from the Bacillus genus, which made visual interpretation slightly more challenging. Even in these cases, the inhibition zones remained within the expected range.
Conclusion
The compatibility study demonstrated that Inneo can be successfully incorporated into all products tested. Its activity remained stable across salad components, dressings, dips, and acidic ingredients, with results comparable to the Inneo 50 ppm standard. Incorporation through the dressing or other liquid components appears to be the most practical and effective approach, ensuring even distribution throughout the recipe. Overall, Inneo proved fully compatible with the customer’s formulations and provides dependable protection against Listeria monocytogenes without affecting product quality, taste, or texture.



